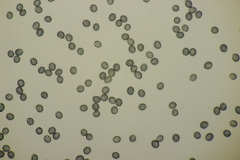
Russula farinipes

Russula farinipes: taxon details and analytics
- Domain
- Kingdom
- Fungi
- Phylum
- Basidiomycota
- Class
- Agaricomycetes
- Order
- Russulales
- Family
- Russulaceae
- Genus
- Russula
- Species
- Russula farinipes
- Scientific Name
- Russula farinipes
Summary description from Wikipedia:
Mehlstiel-Täubling
Der Mehlstiel-Täubling (Russula farinipes) ist ein Pilz aus der Familie der Täublingsverwandten (Russulaceae). Es handelt sich um einen scharfen, elfenbeingelblichen Täubling, der einen auffällig zäh-elastischen Hut hat, der am Rand stark gerieft ist. Seine Lamellen sind blass cremeweiß bis gelblich. Von seinem Erscheinungsbild her ähnelt er dem Fleischroten Speise-Täubling (Russula vesca). Der ziemlich seltene Täubling wächst vor allem unter Laubbäumen auf lehmigen, mehr oder weniger kalkhaltigen Böden.
...Russula farinipes in languages:
- Bokmål
- melfotkremle
- Czech
- holubinka pružná
- Dutch
- Bleekgele russula
- Finnish
- jauhojalkahapero
- French
- Russule à pied farineux
- Hungarian
- korpástönkű galambgomba
- Latvian
- Miltu bērzlape
- Lithuanian
- Tamprioji ūmėdė
- Swedish
- mjölfotskremla
Images from inaturalist.org observations:
We recommend you sign up for this excellent, free service.